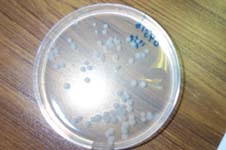

最終更新日 平成12年12月3日

平成12年11月22日(水)、神奈川県伊勢原市の大山豆腐さん
を訪れました。
今回の目的は、発酵するときに納豆菌が作るコロニー(集団)の形
と、その納豆菌でできる納豆がもつ酵素の量(菌体外酵素生産性)に
はどういった関係があるのかを、ナットウキナーゼ6倍の納豆菌を探
しだし、商品化を行った大山豆腐研究開発室の伊部さん、そして熊田
さん(医学博士、つくば国際短大)にお聞きするというものです。
*コロニー
栄養源のある環境(寒天平板など)に落ちた1つの納豆菌が2つ、
4つと増えていって、目に見えるぐらいの塊になったもの。

納豆には、血栓溶解成分として有名になったナットウキナーゼやタ
ンパク質を分解するプロテアーゼなどの酵素が入っているのですが、
数ある納豆菌のなかでも、その酵素を多く作り出す菌とそうでないも
のがあります。
それを区別するために、普通は実際に作って測定するという事を繰
り返すのですが、納豆菌が作るコロニーの形を見ただけである程度判
断できるのではないか、ということを確認したかったわけです。
研究者の方は純粋な研究の一環として興味のあるところだと思いま
すが、私はコロニーのかたちを見ただけで、
「ふっ、これではアミラーゼの多い納豆にはならんな」
(『美味しんぼ』海原雄山風もしくは魯山人風に)
と言いたいだけなので、俗物根性丸出しです。スイマセン。
今回の参加者は、農林水産省の研究者である稲津さん、納豆の品質
管理のお仕事をされているらいきさん、そして私の3名です。
大山豆腐さんに着き、会議室にご案内頂いて、まずはご挨拶。
社員の皆さんは、なぜか胸に「パンタス」と書いた白衣を着ておら
れます。
研究開発室室長でいらっしゃり、以前は製薬会社で発酵関係のお仕
事をされていた恩賀さん、研究開発室の伊部さん、そして熊田さんに
対応して頂きました。
まずは、恩賀さんから大山豆腐さんの会社のご紹介をして頂きまし
た。
豆腐事業だけだった大山豆腐さんが納豆事業に参入してきたのが、
1987年。当時は挽き割り納豆も造っておられたそうですが、納豆
のいく製品ができなかったため、現在は小粒納豆のみとなったそうで
す。確かに挽き割り納豆は難しく、恩賀さん曰く、ヤマダフーズさん
以外の大手メーカー納豆で美味しいものは食べたことがない、とのこ
とです。
大山豆腐さんは、社長が機械の専門家であったことから、日本オペ
レーター株式会社として創業し、1998年に「大山豆腐」に社名変
更されたそうです。
ん?とするとパンタスって何?
「お話の途中でスイマセン。皆さんの胸に『パンタス』と書いて
ありますが、これはどういった意味でしょうか?」
「ああ、それ。パンタスのパンは食べるパンで、タスは味わうとい
う意味です」
という恩賀さんのお答えに
「では、ブレッド(bread)テイスト(taste)という意味でしょうか」
「そうです」
「はっ、そうですか。身が引き締まる思いが致します」
と答え、訳の分からないやりとりになったところで、工場を案内し
て頂きました。
あいにく工場内での生産はお休みでしたが、設備を見る限り機能
的にまとまった工場です。(但し、清掃の際の作業性に若干問題が
ある感じがします)
納豆工場見学も、数多くしてまいりましたので、メーカーさんに
よって色があり、面白いものです。
工場内見学を終え、会議室に戻り、いよいよ納豆菌のお話です。
と、そこで大山豆腐さんの社長、加藤さんのご登場。
せっかくですから、大山豆腐さんの売りであるナットウキナーゼ
6倍納豆の誕生について質問してみます。
横からは、「社長は話が長いんです」「先日、話を聞きながら寝
ちゃいました」という○部さん、○田さんのお声も聞こえましたが、
お聞きしなけばなりません。
「ナットウキナーゼ6倍の菌を使うという発想はどこからお出に
なったのですか?
「死んだんですよ・・・目の前で人が。」
「は、はぁ」
「いやね、アメリカに行ったときにね。
目の前にいた老人の旅行会みたいな人がねぇ・・・・」
と加藤社長の熱いトークが炸裂し、納豆にかける思いが伝わってま
いりました。
要約しますと、9年前に自社で納豆菌の開発をしようと思い、
「美味しい」納豆を造るため、研究開発室を設置。美味しい納豆を
求めていたのですが、商社を通さず大豆を輸入している関係で、加
藤社長がアメリカを訪れたときのこと、目の前でご老人が急に倒れ
お亡くなりになり、それを悲しむ人たちを見て、「食品で何か出来
ないのか」と思いになったそうです。
ちょうどその頃、須見教授のナットウキナーゼ発見のお話があり、
それを目につけた加藤社長、「美味しい納豆」のための納豆菌探し
から、「体にいい納豆(機能性のある)」のための納豆菌探しに
変え、熊田さん、伊部さんの2年間におよぶ調査でナットウキナー
ゼ6倍の納豆菌を見つけたそうです。
加藤社長の熱いトーク、食品を通しての健康への思いがビンビン
伝わりました。
そして、いよいよ納豆菌のお話です。
伊部さんから納豆菌のコロニーの現物数種類、熊田さんから納豆
菌を撮影した資料を見せて頂きました。

結論から言いますと、コロニーを作っていく際に横方向に広がって
いく納豆菌は、ナットウキナーゼなどの酵素を作る量も少なく、上方
向(x軸、y軸、z軸で言えばz軸)にのびる納豆菌は酵素を作る量
が多いということです。写真で見ると、豚のしっぽのようなものが
ピョンと飛び出ているかたちのコロニーです。
また、ナットウキナーゼ(フィブリン溶解活性)とプロテアーゼの
間にも関連性があることから、ナットウキナーゼを多く作る納豆菌は
プロテアーゼも多く作るということが分かりました。
稲津さんからは、プロテアーゼ、アミラーゼなどを作る量は、ナッ
トウキナーゼを作る量と同じ遺伝子の調節を受けているのではという
ご指摘もありました。

酵素をよく作る納豆菌がなぜコロニーを作っていくときに上(z軸)
にのびていくのか、という点については不明ですが、熊田さんの予想
では、「より酸素を求めて上にのびるのでは」ということでした。
熊田さんの予想通りに「より酸素を求める」納豆菌であるなら、酵
素を作る量が多いだけでなく、昨年から話題になっている活性酸素を
食べてくれるSOD(スーパー・オキシド・ジスムターゼ)も多い納
豆になるのではないか、と私は勝手に予想してます。
もしz軸を正確に計測することができ、何mm、上(z軸)にのびた
ら、酵素がどれくらいできるのか、なんていう表ができたら面白いこ
とでしょう。
納豆菌のお話がはじまって約1時間、大変密度の濃いお話をするこ
とができ、「あっ!」という間に時間が経ってしまいました。
私自身、納豆菌への関心がいままで以上に強くなり、今後の納豆活
動への意欲が沸いてきました。
いきなりの見学申し込みにもかかわらず、対応頂きました熊田さん、
伊部さん、そして恩賀さん、加藤社長、ありがとうございました。
*お土産として頂いた「麦とろ納豆」などの主力商品、ありがたく頂
戴致しました。